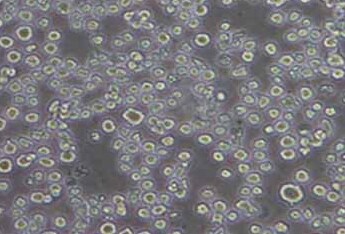
U266 (人多发性骨髓瘤细胞系) (STR鉴定正确) U266 (human multiple myeloma cells) (STR identification correct)

-
蛋白&免疫印迹
蛋白制备 蛋白电泳制胶试剂盒 Tris-Glycine玻璃板预制胶 Tris-Hepes玻璃板预制胶 Bis-Tris塑料板预制胶 大分子蛋白电泳套装(醋酸预制胶) 小分子蛋白电泳套装(Tricine预制胶) 非变性蛋白电泳套装( 非变性预制胶) 蛋白上样缓冲液 蛋白marker 电泳缓冲液&速溶颗粒 蛋白凝胶染色试剂蛋白转印 印迹孵育及检测 蛋白组学试剂蛋白提取试剂(蛋白组学) 蛋白酶(蛋白组学)蛋白电泳及转印仪器&零配件重组胰蛋白酶(质谱级) 重组赖氨酰内切酶(质谱级) IdeZ Protease(免疫球蛋白G降解酶) IdeS Protease(免疫球蛋白G降解酶) PNGase F((N-糖酰胺酶F或肽N-糖苷酶 F) Endo H(糖苷内切酶 H)相关耗材(蛋白组学)
- 抗体&抗原
- 免疫沉淀、免疫共沉淀试剂(IP、Co-IP)
- 免疫组化、免疫荧光
- ELISA 相关产品
- 分子生物学相关产品
- 染色液
- 检测试剂盒
- 细胞培养与检测
- 细胞资源库
- 常规试剂
- 标准溶液
- 动物实验
- 小动物成像
- 生化试剂
- 外泌体试剂
- 常用实验器材
- 圣尔生物明星产品
- 新品推荐
- 圣尔周边
- 技术服务
U266 (人多发性骨髓瘤细胞系) (STR鉴定正确) U266 (human multiple myeloma cells) (STR identification correct) SB-HU3927
圣尔生物share-bio

U266 (人多发性骨髓瘤细胞系) (STR鉴定正确) U266 (human multiple myeloma cells) (STR identification correct)
( 别名:U266-B1; U266 B1; U-266; U 266; U266; U266S; U266BL; U266 Bl; 266 Bl )
| 货 号 | SB-HU3927 | ||
|---|---|---|---|
| 英 文 名 | U266 (human multiple myeloma cells) (STR identification correct) | ||
| 规 格 | T25培养瓶或1 mL冻存管包装 | ||
| 品 牌 | 圣尔生物share-bio | ||
| 一键复制产品信息 | |||
| 产品编号 | 名称 | 包装 | 品牌 | 目录价 | 促销价 | 货期 | 数量 | 购物车 |
| SB-HU3927 | U266 (人多发性骨髓瘤细胞系) (STR鉴定正确) U266 (human multiple myeloma cells) (STR identification correct) | T25培养瓶或1 mL冻存管包装 | 圣尔生物share-bio | ¥1700.00 |
|
U266 (人多发性骨髓瘤细胞系) (STR鉴定正确) U266 (human multiple myeloma cells) (STR identification correct) 介绍
| 产品详情 | 种属 人 别称 U266-B1; U266 B1; U-266; U 266; U266; U266S; U266BL; U266 Bl; 266 Bl 组织来源 B淋巴细胞,外周血 疾病 骨髓瘤 传代比例/细胞消化 1:2传代 完全培养基配置 RPMI1640培养基;10%胎牛血清;1%双抗 简介 该细胞来源于多发性骨髓瘤男性患者,表达IgG,分泌IL-6。 形态 淋巴母细胞样 生长特征 悬浮生长 倍增时间 每周 STR Amelogenin:X,Y;CSF1PO:12,13;D12S391:18,18;D13S317:12,12;D16S539:10,10;D18S51:12,14;D19S433:13,15;D21S11:28,29;D2S1338:20,23;D3S1358:17,17;D5S818:11,12;D6S1043:11,17;D7S820:11,12;D8S1179:13,13;FGA:18,18;Penta E:10,12;TH01:5,7;TPOX:8,8;vWA:17,17; 培养条件 气相:空气,95%;二氧化碳,5%。 温度:37摄氏度,培养箱湿度为70%-80%。 冻存条件 冻存液:90%FBS,DMSO 10%, 保藏机构 ATCC; TIB-196 备注 该细胞为悬浮细胞,请注意离心收集细胞悬液,请勿直接倒掉细胞培养液。 |
|---|---|
| 储存条件及期限 | T25瓶:观察好细胞状态后,75%酒精消毒T25瓶外壁,将T25瓶置于37度培养箱放置2-4h,以便稳定细胞状态后传单;冻存管:收到细胞后,需立即转入液氮冻存或直接复苏 |
搜索质检报告(COA)
搜索MSDS
暂无技术资料
U266 (人多发性骨髓瘤细胞系) (STR鉴定正确) U266 (human multiple myeloma cells) (STR identification correct) 说明书
For research use only. Not intended for human and animal therapeutic or diagnostic use.
线上下单立享积分,加入圣尔会员,礼品随心兑!点击注册






